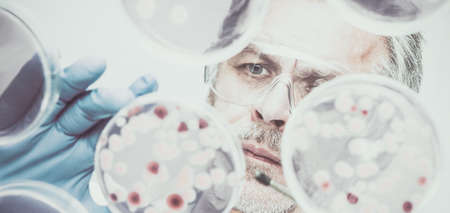
Senior life science researcher grafting bacteria.の写真素材

写真素材 - Senior life science researcher grafting bacteria.
キーワード
- Ebola
- Zika
- analyze
- bacteria
- bio
- biological
- biology
- blue
- cell
- clinical
- close-up
- colony
- culture
- detail
- dish
- experiment
- fluid
- fungi
- gene
- genetics
- glass
- glove
- goggles
- graft
- grow
- healthcare
- laboratory
- life
- liquid
- macro
- man
- medical
- medicine
- micro
- organism
- person
- petri
- pharmacy
- plate
- research
- researcher
- sample
- science
- scientific
- scientist
- senior
- serum
- technology
- test
- virus
類似作品
Abstract Motion...
Senior man carr...
Close up of sen...
Elderly profess...
Professor and h...
Senior scientis...
Senior male res...
Laboratory Rese...
fascinating bio...
Mature scientis...
Professor works...
Professor and h...
Science, medica...
Scientist at wo...
Portrait of mat...
Old researcher ...
Hes just made a...
Science, medica...
The truth lies ...
Professor and h...
close up face o...
Mature lady usi...
I mightve disco...
Professor and d...
Laboratory Rese...
Glass wall, sci...
So serious. Att...
Experienced che...
Smiling senior ...
Senior professo...
Senior chemist ...
Young woman sci...
What do we have...
Close up of mic...
An elderly doct...
This vile seems...
Science teacher...
Analyzing sampl...
Science teacher...
Serious senior ...
Doctor thinking...
Professional do...
Scientist in bl...
Young woman sci...
Saving lives on...
Office of the r...
Mature scientis...
Scientist, seni...
Mature man, sci...